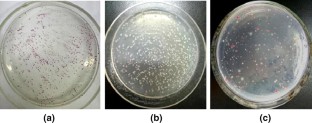

Abstract
Objectives
To screening of bacteria with cyclic amino alcohol deamination activity for enantioselective synthesis of chiral cyclic β-amino alcohols.
Results
A new strain named Arthrobacter sp. TYUT010-15 with the (R)-selective deamination activity of cyclic β-amino alcohol has been isolated from nature via a high throughput solid-phase screening method. The reaction conditions of TYUT010-15 were optimized. Using the resting cell of TYUT010-15 as the catalyst, kinetic resolution of trans-2-aminocyclopentanol, trans-2-aminocyclohexanol and cis-1-amino-2-indanol was carried out to afford (1S, 2S)-trans-2-aminocyclopentanol, (1S, 2S)-trans-2-aminocyclohexanol and (1R, 2S)-cis-1-amino-2-indanol in > 99% ee and 49.6–50% conversion. Four aromatic β-amino alcohols and two amines were also resolved, (S)-β-amino alcohols and (R)-amines were obtained in > 99% ee. Preparation experiment was conducted with 200 mM (23.2 g L−1) racemic trans-2-aminocyclohexanol, yielding the desired (1S, 2S)-trans-2-aminocyclohexanol in 40% isolated yield, > 99% ee and 5.8 g L−1 d−1 space time yields.
Conclusions
This study provides a high throughput solid-phase method for screening of bacteria with cyclic amino alcohol deamination activity and a first example for practical preparation of chiral cyclic β-amino alcohol by Arthrobacter sp. TYUT010-15.

Similar content being viewed by others
References
Arndt HD, Ziemer B, Koert U (2004) Folding propensity of cyclohexylether-δ-peptides. Org Lett 6:3269–3272
Bergmeier SC (2000) The synthesis of vicinal amino alcohols. Tetrahedron 56:2561–2576
Birrell JA, Jacobsen EN (2013) A practical method for the synthesis of highly enantioenriched trans-1,2-amino alcohols. Org Lett 15:2895–2897
Chen FF, Cosgrove SC, Birmingham WR, Mangas-Sanchez J, Citoler J, Thompson MP, Zheng GW, Xu JX, Turner NJ (2019) Enantioselective synthesis of chiral vicinal amino alcohols using amine dehydrogenase. ACS Catal 9:11813–11818
González-Sabín J, Ríos-Lombardía N, Gotor V, Morís F (2013) Enzymatic transesterification of pharmacologically interesting β-aminocycloalkanol precursors. Tetrahedron Asymmetry 24:1421–1425
Govindaraju T, Gonnade RG, Bhadbhade MM, Kumar VA, Ganesh KN (2003) (1S,2R/1R,2S)-Aminocyclohexyl glycyl thymine PNA: synthesis, monomer crystal structures, and DNA/RNA hybridization studies. Org Lett 5:3013–3016
Gupta P, Mahajan N (2018) Biocatalytic approaches towards stereoselective synthesis of vicinal amino alcohols. New J Chem 42:12296–12327
Hu Q, Chen J, Zhang Z, Liu Y, Zhang W (2016) Rh-catalyzed one-pot sequential asymmetric hydrogenation of α-dehydroamino ketones for the synthesis of chiral cyclic trans-β-amino alcohols. Org Lett 18:1290–1293
Hughes G, Lewis JC (2018) Introduction: biocatalysis in industry. Chem Rev 118:1–3
Kawabata T, Yamamoto K, Momose Y, Yoshida H, Nagaoka Y, Fuji K (2001) Kinetic resolution of amino alcohol derivatives with a chiral nucleophilic catalyst: access to enantiopure cyclic cis-amino alcohols. Chem Commun 24:2700–2701
Leisch H, Grosse S, Iwaki H, Hasegawa Y, Lau PCK (2012) Cyclohexylamine oxidase as a useful biocatalyst for the kinetic resolution and dereacemization of amines. Can J Chem 90:39–45
Li QH, Dong Y, Chem FF, Liu L, Li CX, Xu JH, Zheng GW (2018) Reductive amination of ketones with ammonium catalyzed by a newly identified Brevibacterium epidermidis strain for the synthesis of (S)-chiral amines. Chinese J Catal 39:1625–1632
Li GY, Ren J, Iwaki H, Zhang DL, Hasegawa Y, Wu QQ, Feng JH, Lau PCK, Zhu DM (2014) Substrate profiling of cyclohexylamine oxidase and its mutants reveals new biocatalytic potential in deracemization of racemic amines. Appl Microbiol Biotechnol 98:1681–1689
Liu S, Xie JH, Li W, Kong WL, Wang LX, Zhou QL (2009) Highly enantioselective synthesis of chiral cyclic amino alcohols and conhydrine by Ruthenium-catalyzed asymmetric hydrogenation. Org Lett 11:4994–4997
Luna A, Astorga C, Fülöp F, Gotor V (1998) Enzymatic resolution of (±)-cis-2-aminocyclopentanol and (±)-cis-2-aminocyclohexanol. Tetrahedron Asymmetry 9:4483–4487
Maestro A, Astorga A, Gotor V (1997) Enzymatic resolution of (±)-trans-2-aminocyclohexanol and (±)-trans-2-aminocyclopentanol. Tetrahedron Asymmetry 8:3153–3159
Martinez LE, Leighton JL, Carsten DH, Jacobsen EN (1995) Highly enantioselective ring opening of epoxides catalyzed by (salen) Cr (III) complexes. J Am Chem Soc 117:5897–5898
Mutti FG, Fuche CS, Pressnitz D, Turrini NG, Sattler JH, Lerchner A, Skerra A, Kroutil W (2012) Amination of ketones by employing two new (S)-selective ω-transaminases and the his-tagged ω-TA from Vibrio fluvialis. Eur J Org Chem 5:1003–1007
Nagata T, Yoshino T, Haginoya N, Yoshikawa K, Isobe Y, Furugohri T, Kanno H (2007) Cycloalkanediamine derivatives as novel blood coagulation factor Xa inhibitors. Bioorg Med Chem Lett 17:4683–4688
Overman LE, Sugai S (1985) A convenient method for obtaining trans-2-aminocyclohexanol and trans-2-aminocyclopentanol in enantiomerically pure form. J Org Chem 50:4154–4155
Patil MD, Grogan G, Bommarius A, Yun H (2018) Oxidoreductase-catalyzed synthesis of chiral amines. ACS Catal 8:10985–11015
Polakovič M, Švitel J, Bučko M, Filip J, Neděla V, Ansorge-Schumacher MB, Gemeiner P (2017) Progress in biocatalysis with immobilized viable whole cells: systems development, reaction engineering and applications. Biotechnol Lett 39:667–683
Rouf A, Gupta P, Aga MA, Kumar B, Parshad R, Taneja SC (2011) Cyclic trans-β-amino alcohols: preparation and enzymatic kinetic resolution. Tetrahedron Asymmetry 22:2134–2143
Schiffers I, Rantanen T, Schmidt F, Bergmans W, Zani L, Bolm C (2006) Resolution of racemic 2-aminocyclohexanol derivatives and their application as ligands in asymmetric catalysis. J Org Chem 71:2320–2331
Schiffers I, Bolm C (2008) Synthesis and resolution of racemic trans-2-(N-Benzyl) amino-1-cyclohexanol: enantiomer separation by sequential use of (R)- and (S)-mandelic acid. Org Synth 85:106–117
Senanayake CH, Dimichele LM, Liu J, Fredenburgh LE, Ryan KM, Roberts EF, Larsen RD, Verhoeven TR, Reider PJ (1995) Regio- and stereocontrolled syntheses of cyclic chiral cis-amino alcohols from 1, 2-diols or epoxides. Tetrahedron Lett 36:7615–7618
Sheldon RA, Pereira PC (2017) Biocatalysis engineering: the big picture. Chem Soc Rev 46:2678–2691
Trivedi BK, Janak K, Padia JK, Holmes A, Rose S et al (1998) Second generation “Peptoid” CCK-B receptor antagonists: identification and development of N-(adamantyloxycarbonyl)-α-methyl-(R)-tryptophan derivative (CI-1015) with an improved pharmacokinetic profile. J Med Chem 41:38–45
Zhang JD, Wu HL, Meng T, Zhang CF, Fan XJ, Chang HH, Wei WL (2017) A high-throughput microtiter plate assay for the discovery of active and enantioselective amino alcohol-specific transaminases. Anal Biochem 518:94–101
Zhang JD, Yang XX, Jia Q, Zhao JW, Gao LL, Gao WC, Chang HH, Wei WL, Xu JH (2019a) Asymmetric ring opening of racemic epoxides for enantioselective synthesis of (S)-β-amino alcohols by a cofactor self-sufficient cascade biocatalysis system. Catal Sci Technol 9:70–74
Zhang JD, Zhao JW, Gao LL, Chang HH, Wei WL, Xu JH (2019b) Enantioselective synthesis of enantiopure β-amino alcohols via kinetic resolution and asymmetric reductive amination by a robust transaminase from Mycobacterium vanbaalenii. J Biotechnol 290:24–32
Acknowledgements
This work was supported by the National Natural Science Foundation of China (Grant No. 21772141) and the Shanxi Province Science Foundation for Youths (Grant No. 201701D221042).
Supporting information
Supplementary Table 1—Kinetic resolution of racemic trans-2-aminocyclohexanol 1b by the isolated strains.
Supplementary Figure 1—Phylogenetic dendrogram for isolated strain based on the 16S rRNA gene sequence.
Supplementary Figure 2 to 9—Chiral GC analysis of 1a–3b.
Supplementary Figure 10—Chiral HPLC analysis of cis-1c.
Author information
Authors and Affiliations
Corresponding author
Additional information
Publisher's Note
Springer Nature remains neutral with regard to jurisdictional claims in published maps and institutional affiliations.
Electronic supplementary material
Below is the link to the electronic supplementary material.
Rights and permissions
About this article
Cite this article
Chang, YW., Zhang, JD., Yang, XX. et al. High throughput solid-phase screening of bacteria with cyclic amino alcohol deamination activity for enantioselective synthesis of chiral cyclic β-amino alcohols. Biotechnol Lett 42, 1501–1511 (2020). https://doi.org/10.1007/s10529-020-02869-2
Received:
Accepted:
Published:
Issue Date:
DOI: https://doi.org/10.1007/s10529-020-02869-2




